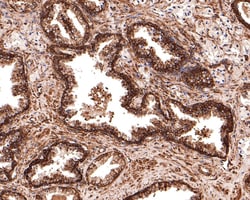
Invitrogen MST4 Recombinant Rabbit Monoclonal Antibody (JE64-64) 100 &mu;L;

missing translation for 'onlineSavingsMsg'
Learn More
Learn More
Invitrogen™ MST4 Recombinant Rabbit Monoclonal Antibody (JE64-64)


Rabbit Recombinant Monoclonal Antibody
Brand: Invitrogen™ MA544714
This item is not returnable.
View return policy
Description
MST4 Recombinant Monoclonal Antibody for Western Blot, IHC (P)
MST4 is member of the Ste20-like kinase family of serine/threonine kinases and is overexpressed during prostate cancer development. The product of this gene is a member of the GCK group III family of kinases, which are a subset of the Ste20-like kinases. The encoded protein contains an amino-terminal kinase domain, and a carboxy-terminal regulatory domain that mediates homodimerization. The protein kinase localizes to the Golgi apparatus and is specifically activated by binding to the Golgi matrix protein GM130. It is also cleaved by caspase-3 in vitro, and may function in the apoptotic pathway. Several alternatively spliced transcript variants of this gene have been described, but the full-length nature of some of these variants has not been determined.
Specifications
| MST4 | |
| Recombinant Monoclonal | |
| 1 mg/mL | |
| TBS with 0.05% BSA, 40% glycerol and 0.05% sodium azide; pH 7.4 | |
| Q99JT2, Q9P289 | |
| Stk26 | |
| Recombinant protein within human MST4 aa aa 317-416/416. | |
| 100 μL | |
| Primary | |
| Human, Mouse, Rat | |
| Antibody | |
| IgG |
| Immunohistochemistry (Paraffin), Western Blot | |
| JE64-64 | |
| Unconjugated | |
| Stk26 | |
| 2610018G03Rik; Mammalian STE20-like protein kinase 4; mammalian sterile 20-like 4; Mask; Mst3 and SOK1-related kinase; Mst4; MST-4; OTTHUMP00000215132; OTTHUMP00000215134; RGD1563568; RP6-213H19.1; serine/threonine kinase 26; serine/threonine protein kinase 26; serine/threonine protein kinase MST4; serine/threonine-protein kinase 26; Serine/threonine-protein kinase MASK; serine/threonine-protein kinase MST4; STE20-like kinase 4; STE20-like kinase MST4; STK26 | |
| Rabbit | |
| Protein A | |
| RUO | |
| 317589, 51765, 70415 | |
| Store at 4°C short term. For long term storage, store at -20°C, avoiding freeze/thaw cycles. | |
| Liquid |
Product Content Correction
Your input is important to us. Please complete this form to provide feedback related to the content on this product.
Product Title
Spot an opportunity for improvement?Share a Content Correction